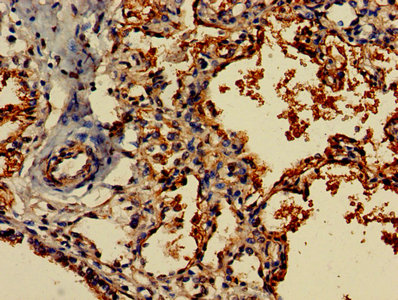
CSB-PA008734LA01HU

FLT3LG
FLT3LG,即FMS相關酪氨酸激酶3配體,別名FLT3配體。FLT3LG是一種在人類中由FLT3LG基因編碼的蛋白質。它的作用機制是通過激活其受體FLT3來促進早期造血細胞的增殖,與其他多種集落刺激因子和白細胞介素具有很好的協同作用。FLT3LG通過與FLT3受體結合,觸發受體的同源二聚體化和自身磷酸化,從而激活PI3K/AKT和Ras/MAPK等下游信號通路,啟動生長和分化級聯反應。FLT3LG在生物學上的意義主要體現在其對造血干細胞和祖細胞(HSPC)的增殖和分化的調控上。FLT3LG基因的突變可以導致嚴重的免疫缺陷,表現為骨髓發育不全、HSPC顯著減少,以及單核細胞和樹突狀細胞的缺乏。此外,FLT3LG對于單核細胞和樹突狀細胞的分化至關重要,這些細胞在人體的免疫防御中發揮著關鍵作用。FLT3LG的發現不僅擴展了我們對控制造血譜系發育的分子機制的理解,還強調了FLT3LG在免疫防御中的重要作用,特別是在針對包括HPV在內的各種病原體的免疫應答中。
熱銷產品
FLT3LG Antibody (CSB-PA008734LA01HU)
驗證數據

Immunofluorescence staining of MCF-7 cells with CSB-PA008734LA01HU at 1:266, counter-stained with DAPI. The cells were fixed in 4% formaldehyde, permeabilized using 0.2% Triton X-100 and blocked in 10% normal Goat Serum. The cells were then incubated with the antibody overnight at 4°C. The secondary antibody was Alexa Fluor 488-congugated AffiniPure Goat Anti-Rabbit IgG(H+L).
IHC image of CSB-PA008734LA01HU diluted at 1:800 and staining in paraffin-embedded human lung tissue performed on a Leica BondTM system. After dewaxing and hydration, antigen retrieval was mediated by high pressure in a citrate buffer (pH 6.0). Section was blocked with 10% normal goat serum 30min at RT. Then primary antibody (1% BSA) was incubated at 4°C overnight. The primary is detected by a biotinylated secondary antibody and visualized using an HRP conjugated SP system.
FLT3LG Antibodies
FLT3LG for Homo sapiens (Human)
| 產品貨號 | 產品名稱 | 種屬反應性 | 應用類型 |
|---|---|---|---|
| CSB-PA008734LA01HU | FLT3LG Antibody | Human | ELISA, IHC, IF |
| CSB-PA008734LB01HU | FLT3LG Antibody, HRP conjugated | Human | ELISA |
| CSB-PA008734LC01HU | FLT3LG Antibody, FITC conjugated | Human | |
| CSB-PA008734LD01HU | FLT3LG Antibody, Biotin conjugated | Human | ELISA |
| CSB-PA778110 | FLT3LG Antibody | Human | ELISA,WB |
| CSB-PA002551 | FLT3LG Antibody | Human | WB, IHC, ELISA |
| CSB-PA006021 | FLT3LG Antibody | Human | WB, ELISA |
FLT3LG Proteins
FLT3LG Proteins for Homo sapiens (Human)
| 產品貨號 | 產品名稱 | 來源 |
|---|---|---|
| CSB-YP008734HU1 CSB-BP008734HU1 CSB-EP008734HU1-B |
Recombinant Human Fms-related tyrosine kinase 3 ligand (FLT3LG), partial | Yeast Baculovirus In Vivo Biotinylation in E.coli |
| CSB-AP002201HU | Recombinant Human Fms-related tyrosine kinase 3 ligand protein (FLT3LG), partial (Active) | E.Coli |
| CSB-CF008734HU | Recombinant Human Fms-related tyrosine kinase 3 ligand (FLT3LG) | in vitro E.coli expression system |
| CSB-EP008734HU1 | Recombinant Human Fms-related tyrosine kinase 3 ligand (FLT3LG), partial | E.coli |
| CSB-AP005901HU | Recombinant Human Fms-related Tyrosine Kinase 3 Ligand (FLT3LG), partial (Active) (GMP) | E.Coli |
| CSB-MP008734HU-WD | Recombinant Human Fms-related tyrosine kinase 3 ligand (FLT3LG),Partial (Active) | Mammalian cell |
FLT3LG Proteins for Mus musculus (Mouse)
| 產品貨號 | 產品名稱 | 來源 |
|---|---|---|
| CSB-YP008734MO1 CSB-EP008734MO1 CSB-BP008734MO1 CSB-MP008734MO1 CSB-EP008734MO1-B |
Recombinant Mouse Fms-related tyrosine kinase 3 ligand (Flt3lg), partial | Yeast E.coli Baculovirus Mammalian cell In Vivo Biotinylation in E.coli |
| CSB-CF008734MO | Recombinant Mouse Fms-related tyrosine kinase 3 ligand (Flt3lg) | in vitro E.coli expression system |
FLT3LG ELISA Kit
FLT3LG ELISA Kit for Homo sapiens (Human)
| 產品貨號 | 產品名稱 | 樣本類型 | 靈敏度 |
|---|---|---|---|
| CSB-E04554h | Human FMS-like tyrosine kinase 3 ligand,Flt-3L ELISA Kit | serum, plasma,tissue homogenates | 1.95 pg/mL |
FLT3LG ELISA Kit for Mus musculus (Mouse)
| 產品貨號 | 產品名稱 | 樣本類型 | 靈敏度 |
|---|---|---|---|
| CSB-E04555m | Mouse FMS-like tyrosine kinase 3 ligand,Flt-3L ELISA Kit | serum, plasma, tissue homogenates | 3.9 pg/mL |












